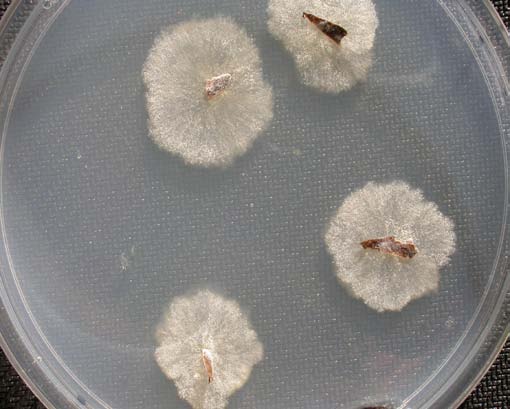
Typical colony formation of Geosmithia morbida growing out of bark chips placed on a Petri plate.

Walnut Twig Beetle and Thousand Cankers Disease of Black Walnut
For at least the past decade, an unusual decline of black walnut (Juglans nigra) has been observed in several western states. Initial symptoms involve a yellowing and thinning of the upper crown, which progresses to include death of progressively larger branches (Figure 1). During the final stages large areas of foliage may rapidly wilt. Trees often are killed within three years after initial symptoms are noted. Tree mortality is the result of attack by the walnut twig beetle (Pityophthorus juglandis) and subsequent canker development around beetle galleries caused by a fungal associate (Geosmithia sp.) of the beetle (Figure 2). The name for this insect disease complex is thousand cankers disease (TCD) of walnut.
Figure 1.
Figure 2.


Walnut Twig Beetle
Distribution. The walnut twig beetle is native to North America and was originally described in 1928 based on specimens collected in the area of “Lone Mountain”, New
Mexico (Grant County). In the 1992 catalog of Bark and Ambrosia Beetles by Wood and Bright the primary range of the insect was listed to include New Mexico, Arizona, and Chihuahua, Mexico. This range appears to coincide largely with the distribution
of Arizona walnut (J. major), the original native host. There is also evidence that walnut twig beetle may be native to California, where it would have been associated with southern California walnut, Juglans californica. In Arizona walnut the insect functions as a “typical” twig beetle, confining its development to overshaded or injured small
diameter limbs and functioning as a natural pruning agent.
The first published record of black walnut mortality associated with the walnut twig beetle was in the Espanola Valley of northern New Mexico where large numbers of mature black walnut died in 2001. However, this may have been preceded in Utah where undetermined black walnut mortality occurred in the early 1990s along the Wasatch Front; a Utah record of the beetle dates to 1988. Similar widespread decline also occurred about this time in the Boise-Meridian area of Idaho where the twig beetle was first confirmed present in 2003. Black walnut mortality has been noted in some Front Range communities in Colorado since 2001 and the twig beetle has been confirmed present in the state since 2004. In those communities where the insect has been
detected, the majority of black walnut has since died. P. juglandis has been recorded from Oregon (Portland) since 1997, has been commonly captured in funnel traps in The Dalles since 2004, and is suspected of being associated with recent widespread death of Juglans spp. in the Willamette Valley of Oregon. Mortality associated with the presence of walnut twig beetle was reported from the Prosser area of Washington in 2008.
In July 2010, the walnut twig beetle and Geosmithia morbida were found in Knoxville, TN. This is a highly significant discovery because it is the first report of TCD appearing within the native range of black walnut. The outbreak in the Knoxville area is extensive throughout the county, indicating the disease was originally introduced with infective walnut twig beetles for a considerable period.
Prior to these recent reports, walnut twig beetle had never been associated with Juglans mortality. In most areas where the die-offs of black walnut have occurred, drought was originally suspected as the cause of the decline and death of trees, with the beetle as a secondary pest. The widespread area across which Juglans spp. die-off have been recently reported, the documented presence of an associated canker-producing fungal pathogen carried by the twig beetle, and the occurrence of black walnut death in irrigated sites not sustaining drought, all suggested an alternate underlying cause – thousand cankers disease.
Description. The walnut twig beetle Pityophthorus juglandis is a minute (1.5-1.9 mm)
yellowish-brown bark beetle, about 3X as long as it is wide. It is the only Pityophthorus species associated with Juglans but can be readily distinguished from other members of the genus by several physical features (Figures 3 and 4). Among these are 4 to 6 concentric rows of asperities on the prothorax, usually broken and overlapping at the median line. The declivity at the end of the wing covers is steep, very shallowly bisulcate, and at the apex it is generally flattened with small granules.
Figure 3. Walnut twig beetle, side view.
Figure 4. Walnut twig beetle, top view.


Life History and Habits. Despite its small size – and common name – attacks by adult P.
juglandis and larval development in black walnut rarely occur in twigs. Instead tunneling is almost always confined to branches greater than 2 cm diameter. Very large branches and even the trunk can be colonized during advanced stages of TCD.
The life history is imperfectly understood. In areas with cold winters such as Colorado, overwintering is spent primarily and possibly exclusively, in the adult stage sheltered within cavities excavated in the bark of the trunk. Overwintering may also occur in larval stages, particularly where winters are mild. Adults resume activity by late-April – beginning as early as March in California. Most fly to branches to mate, within a chamber under the bark, and females initiate egg gallery tunnels (Figure 5). Larvae feed for 4-6 weeks under the bark in meandering tunnels that run perpendicular to the egg gallery (Figure 6). Pupation occurs at the end of the tunnel and the adults emerge through minute, round exit holes.
Figure 5.
Figure 6.


Adults emerge to produce a second generation in early summer. Peak flight activity of adults occurs from mid-July through late August and declines by early fall as the beetles enter hibernation sites. A small number of beetles produced from eggs laid late in the season may not complete development until November and some larval development may continue throughout winter, particularly in warmer areas.
Cankers caused by Geosmithia
Figure 7.

sporulating Geosmithia exposed from under bark.
The walnut twig beetle, normally and perhaps invariably, carries spores of Geosmithia morbida as an external contaminant on its body (Figure 7). When the beetle tunnels into limbs, the fungus also colonizes the gallery walls and adjacent bark tissue. The extent of subsequent colonization of the bark and associated necrosis, called a canker, is dependent on the susceptibility of the host.
In Arizona walnut, the native host of the beetle, cankers are limited and superficial. The tree’s defenses quickly seal off tissue damaged by the fungus and very little branch injury occurs. In contrast, black walnut is highly susceptible to canker formation by this Geosmithia and trees can be killed from the accumulated effects of large, coalescing cankers that develop on this species. The susceptibility of other native walnuts, including northern (J. hindsii) and southern (J. californica) California walnuts, and little walnut (J. microcarpa) as well as the cultivated nut-producing species English walnut (Juglans regia) appear to show various levels of intermediate resistance to the Geomithia fungus and subsequent development of thousand cankers disease. Other kinds of nut-bearing trees, such as hickories and pecan, are immune to thousand cankers disease.
Figure 8.
In black walnut, dark brown to black cankers develop around each beetle gallery. These cankers are initially small, but expand rapidly and soon coalesce (Figures 2 and 8). The depth of the cankering in the bark is variable; some cankers only kill tissue (phloem) next to the outer bark whereas others extend deep into the inner bark to the wood. As a result, the inner bark develops a marbled appearance of healthy and dead phloem. Eventually all of the inner bark is killed and the branch dies. The number of cankers that are formed on branches and the trunk is enormous; hence the name thousand cankers to describe the disease.

Unlike many open-faced canker diseases such as butternut and Nectria cankers, the outer bark on black walnut affected by TCD remains largely intact and doesn’t slough off. Thus the extent of canker development isn’t readily apparent until the outer bark is mechanically removed (Figure 8).
Many other insects and fungi can be found in bark macerated by the walnut twig beetle and Geosmithia during the final stages of the disease. For example ambrosia beetles and the fungus Fusarium solani may be found in the wood of severely damaged trees. However, they are not associated with early stages of TCD. No other insects, aside from walnut twig beetle, have the close association with the Geosmithia fungus and a cambium tunneling habit that allow significant involvement in the development of thousand cankers disease.
The exact mechanism of how thousand cankers ultimately produces tree death is not known but appears to result from progressive depletion of energy reserves of the plant. It is speculated that the cankers disrupt the movement of nutrients through the plant and subsequent storage in roots. Photosynthesis efficiency may also be affected by the effects of cankers on nutrient movement. As energy reserves become exhausted during end stages of the disease the trees rapidly decline and dieback accelerates. When removed TCD-killed trees will produce few, if any sprouts.
Detection of Thousand Cankers Disease
Detection of thousand cankers is very difficult in the early stages of the disease. At present, detection is generally possible only if external symptoms are expressed, which may only occur 5-10 years – or perhaps much longer, after the tree is initially infested.
Figure 9.

Initial symptoms most often appear as yellow flagging of smaller branches. These are often in the upper crown but may be scattered (Figure 9). The crown may also show a general thinning and limbs with symptomatic flagging later die. During end stages of the disease there may be extensive areas of foliage wilting. In the Rocky Mountain States black walnut trees will typically be dead within 2-3 years after initial foliar symptoms are observed.
Differences in symptoms progression may occur in climates with higher rainfall and where growing conditions for black walnut are more favorable. There, initial dieback may be more confined to the upper crown and dense bushy growth may develop in the lower canopy before the disease ultimately progresses to tree death (Figure 10). It is also likely that trees growing under more optimum conditions will see slower progression of disease symptoms than trees in less favorable sites.
Confirmation of the disease requires examination of symptomatic limbs for the presence of either walnut twig beetle activity (e.g., live stages, tunneling, exit holes) or Geosmithia
morbida. Perhaps the easiest means of detection is to sample flagging or recently killed limbs and examine them for the minute exit holes of the walnut twig beetle (Figure 11).
Figure 10.
Figure 11.

Tennessee

Shallow peeling of the bark at these sites will also reveal the characteristic tunneling of the beetles. Despite the name, Pityophthorus juglandis does not colonize the smaller twigs. Limbs 2-5 cm diameter with smooth bark are probably easiest for locating evidence of the insect.
Figure 12.
Detecting cankers produced by Geosmithia morbida requires examining live branches where TCD symptoms are present; wood becomes generally discolored on older dead branches and cankers cannot be distinguished. Geosmithia morbida is readily isolated and produces distinctive colonies when cultured from wood chips, walnut twig beetles, or beetle frass (Figure 12).
growing out of bark chips placed on a Petri plate.
Detection surveys are best done during July and August. Earlier in the season, flagging
symptoms may not yet become expressed and develop only later with higher temperatures and more environmental stress. Late in the season limb flagging may become common on many limbs compromised by other factors, such as mechanical injuries and overshading. Surveys can be completed by leaf yellowing and premature leaf drop, which can have many biotic (e.g., mites, aphids) or abiotic (e.g., drought) causes. However, these produce crown thinning broadly through the canopy whereas thousand cankers disease typically produces more limited symptoms affecting individual limbs.
At present there are no traps that effectively capture walnut twig beetles when at low population. They may incidentally be captured on sticky traps and in Lindgren funnels but these have poor efficiency of capture. Sex pheromones with some attractant activity are produced by walnut twig beetle and these are currently being developed for use in lures that should increase the ability to trap this insect.
Management
Effective controls for TCD have not yet been identified. If they exist, their development will
require better understanding of the biology of the walnut twig beetle and the canker-producing Geosmithia fungus.
The ability of insecticides to help manage TCD appears to be limited. Although the beetles are very susceptible to many commonly used bark beetle insecticides (e.g., carbaryl, various pyrethroids), persistent coverage is very difficult to achieve and maintain due to the extended period when adult beetles are active and the extensive areas of the trees that are colonized; arborists that have attempted to control TCD with trunk sprays have not been able to prevent progression of thousand cankers in trees showing early symptoms. Furthermore, colonization of the bark and cambium by Geosmithia may continue even if adult beetles or larvae are killed by the insecticide. The involvement of the fungus, that colonizes areas ahead of beetle tunneling, also will likely limit the ability of systemic insecticides to effectively move in plants in a manner to kill beetles. Furthermore, the use of insecticides, and any pesticides, are further limited by the regulatory status of black walnut, which is considered a nut-bearing crop.
Similarly, sanitation practices (such as those used so effectively in control of Dutch elm disease) have more modest effectiveness in management of TCD. This is due in large part to the long lag time (years) between when trees are initially infested by twig beetles and when symptoms become visible. During this period, the beetles likely will have spread widely within a TCD-infested area, preventing effective containment. Control is also made difficult since all walnut twig beetles likely carry the Geosmithia fungus.
However a vigorous program to identify black walnuts showing early symptoms and then removing them to prevent further spread of walnut twig beetles may be useful in slowing the spread of thousand cankers with an affected community. The wood from TCD-infected trees should be removed as soon as possible and all wood handled in a way to prevent further spread of walnut twig beetles. Chipping is considered the best management approach, although some beetles will survive this treatment on larger fragments. Alternately the wood may be buried or held in a secure location that is well isolated from areas where TCD is not present.
These management limitations make it extremely critical that the walnut twig beetle not be allowed to spread from infested areas. The most likely means of long-distance spread is through human movement of salvaged TCD-infected logs or firewood that contains walnut twig beetles. Dying trees and recently cut walnut wood produces enormous numbers of walnut twig beetles each contaminated with the Geosmithia fungus. Even a small scrap of walnut with bark intact can support developing walnut twig beetles that can start new infestations.
Since early 2010 several states have established quarantines that prevent the movement of certain walnut products. It is likely that many more will follow. These all regulate raw walnut wood material with bark intact although details may differ regarding accepted means of disinfestation. Most do allow transport of wood that has been milled to remove all bark and wood that has been incorporated into finished products. Also, nuts do not harbor walnut twig beetles and are not regulated by quarantines.
Additional Resource
LINK